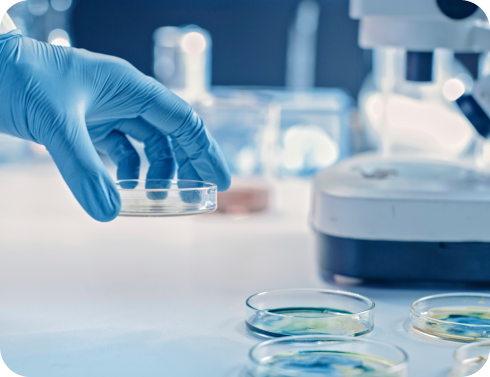

- 東京都卵子凍結助成登録医療機関
- 東京メトロ表参道駅徒歩7分
- 生殖医療専門医在籍
- 心理カウンセラー在籍
- 保険診療・自由診療
- PGT-A認定施設
- 静脈麻酔選択可能

東京HARTクリニック
の特徴
FEATURE

患者様個人に合わせた
オーダーメイドの治療
人の顔が一人一人違うように、卵巣もまた個人差があり、
画一的な方法で皆がうまくいくようなやり方はありません。
当院では世界のスタンダードである卵巣刺激法を主に行っていますが、それにも何種類かの方法があり、前周期での準備や注射の種類を含めると多様な選択肢があります。
その中からその人にあったやり方を見極めることが息子良好な卵子を得る上で最も重要です。

確かな治療技術
20年を超えて培われた経験と技術を受け継ぎながら、
世界最先端の不妊治療を提供しています。
ARTの治療レベルは、半分は卵巣刺激法の計画や移植方法の選択といった部分に依存しますが、もう半分はラボの品質に依存しており、培養士の技術や胚の培養環境は非常に重要です。
将来人間になる命を預かっているのですから、ベストな環境で卵を扱う必要があるのは当然です。

徹底した安全管理
生殖補助医療(ART)では、患者様の精子・卵子を採取、胚を体外で培養、更にそれらを長期に亘って凍結保存するため、治療技術はもちろんのこと、安全・安心対策の充実が求められます。
そのため東京HARTクリニックでは徹底した安全管理教育に加え、バーコードによる認証システムを導入しています。
バーコードによる安全管理システムでは、患者様のお名前・IDの情報を2次元バーコードに登録し、排卵時・精液提出時・体外受精・胚移植などすべての段階で確認を行います。

臍帯幹細胞由来上清液に
よる治療
車 博士(医学)(M.D., Ph.D.)は、45年間、患者様中心の革新的な治療法開発に献身しています。
彼の豊富な経験と専門性は、CHAバイオグループが開発する細胞治療薬のグローバル展開と商業化を通じて、患者様の皆様に新たな希望をもたらすことでしょう。
今後も車 博士と彼の研究チームたちは、患者様の生活の質向上を目指して、研究開発に全力を尽くしてまいります。
診療案内
MEDICAL CONTENT
保険診療を
ご希望の患者様へ
一般不妊治療も生殖補助医療も、
保険での治療をご希望される場合は以下をご確認いただき、
必要書類をご用意の上、ご来院くださいませ。
- 01
保険診療をご希望の患者様へ - 02
自費診療で広がる選択肢 - 03
先進医療について - 04
卵子凍結保存を希望する方へ - 05
難治性不妊症
- 01
保険診療をご希望の患者様へ - 02
自費診療で広がる選択肢 - 03
先進医療について - 04
卵子凍結保存を希望する方へ - 05
難治性不妊症
- 01
保険診療をご希望の患者様へ - 02
自費診療で広がる選択肢 - 03
先進医療について - 04
卵子凍結保存を希望する方へ - 05
難治性不妊症
診療案内
MEDICAL CONTENT
卵子凍結保存を希望する方へ
女性の卵子数は、胎児期の500~700万個をピークとして出生時には
100~200万個まで減少し、その後も年齢が上がるごとに減り続け、
増えることはありません。
- 01
保険診療をご希望の患者様へ - 02
自費診療で広がる選択肢 - 03
先進医療について - 04
卵子凍結保存を希望する方へ - 05
難治性不妊症
- 01
保険診療をご希望の患者様へ - 02
自費診療で広がる選択肢 - 03
先進医療について - 04
卵子凍結保存を希望する方へ - 05
難治性不妊症
コンセプトムービー
OUR CONCEPT MOVIE
令和7年4月から 世界三大不妊治療機関である
CHA University Global IVF Group ファミリーになりました。
施設・設備紹介
FACILITY
落ち着いた雰囲気の広い空間・
最新の医療設備をご用意し、
患者様が安心して診察を受けることのできる
環境づくりをつとめています。

医院情報
INFORMATION
| 診療時間 | 月 | 火 | 水 | 木 | 金 | 土 | 日祝 |
|---|---|---|---|---|---|---|---|
| 午前 9:00~12:00 | ● | ● | ● | ● | ● | ● | - |
| 午後15:00~18:00 | ● | ● | - | ● | ● | - | - |
※ 休診日:日曜・祝日 / 水曜午後・土曜午後
※最終受付時間(AM11:30 / PM17:30)
※診療時間内であっても、予約患者様の診察が終了した時点でクリニックの業務を終了いたします。
-
・〒107-0062 港区南青山5-4-19
ジ・アッパーレジデンシィーズ・ミナミアオヤマ1F
・東京メトロ表参道駅徒歩7分 -
初診予約・お問い合わせ
03-5766-3660 - 再診予約

